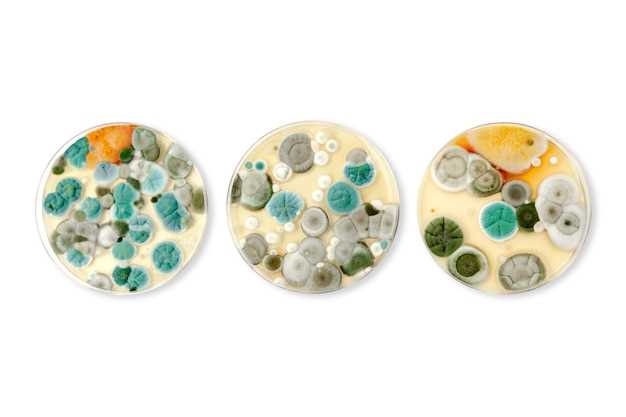
Usage Instructions

Pantoprazole domperidone combination
2026-03-17Are you looking for effective relief from acid reflux and digestive issues? Look no further than our Pantoprazole Domperidone combination! This powerful duo works together to provide fast and lasting relief from heartburn, indigestion, and other stomach problems.
Don't let gastrointestinal issues hold you back – try Pantoprazole Domperidone combination today and experience the difference!
Benefits of Combination
When it comes to the combination of Pantoprazole and Domperidone, the benefits are numerous.
| 1. Dual Action: | The combination of Pantoprazole and Domperidone provides dual action, helping to treat both acid reflux and gastric motility disorders. |
| 2. Effective Relief: | Patients can experience effective relief from symptoms such as heartburn, indigestion, bloating, and nausea due to the synergistic effects of these two medications. |
| 3. Fast-Acting: | The combination acts quickly to provide relief, allowing patients to feel better sooner and resume their daily activities without discomfort. |
| 4. Improved Digestion: | Domperidone helps to improve gastric motility, ensuring that food moves through the digestive system effectively and reducing symptoms like bloating and discomfort after meals. |
| 5. Enhanced Quality of Life: | By alleviating symptoms of acid reflux and aiding digestion, the Pantoprazole-Domperidone combination can significantly improve the quality of life for individuals suffering from gastrointestinal issues. |
Benefits of Combination
The combination of Pantoprazole and Domperidone offers several benefits for managing acid-related disorders in the stomach. Here are some key advantages:
1. Dual Action:
Pantoprazole reduces the production of stomach acid, while Domperidone helps to regulate digestion by increasing the movement of food through the digestive system. This dual action helps to alleviate symptoms of conditions such as acid reflux and indigestion effectively.
2. Faster Relief:

The combination of Pantoprazole and Domperidone provides faster relief from symptoms compared to using each medication alone. This can help improve overall comfort and quality of life for individuals suffering from gastrointestinal issues.
- Enhanced Effectiveness
- Improves Digestive Health
- Minimizes Acid-related Symptoms
By combining these two medications, patients can experience improved symptom relief and better management of acid-related disorders, leading to a higher quality of life.
Usage Instructions
1. Dosage:
Take Pantoprazole Domperidone combination as directed by your healthcare provider. Typically, the recommended dosage is one tablet daily before a meal. Do not exceed the prescribed dosage without consulting your doctor.
2. Administration:
Swallow the tablet whole with a glass of water. Do not crush, chew, or break the tablet as it may affect the effectiveness of the medication.
3. Timing:
Take the medication at the same time each day to maintain a consistent level of the drug in your system and maximize its benefits.
4. Duration:
Continue taking Pantoprazole Domperidone combination for the full prescribed duration, even if you start feeling better before the course is completed. Stopping the medication prematurely may result in a relapse of symptoms.
5. Side Effects:
Monitor for any potential side effects such as nausea, headache, or abdominal discomfort. If you experience any severe or persistent side effects, seek medical attention immediately.
Remember to follow your doctor's instructions and guidance for optimal results and safety.
Customer Reviews
Customer 1: After using Pantoprazole Domperidone Combination for a few weeks, I noticed a significant improvement in my indigestion issues. The combination worked wonders for me, and I no longer experience discomfort after meals.
Customer 2: I have been struggling with acid reflux for years, and this product has been a game-changer for me. The relief was almost instant, and I feel much better overall. Highly recommended!
Customer 3: I was skeptical at first, but after trying this combination, I can confidently say that it is the best solution for my digestive problems. No more bloating or heartburn for me!